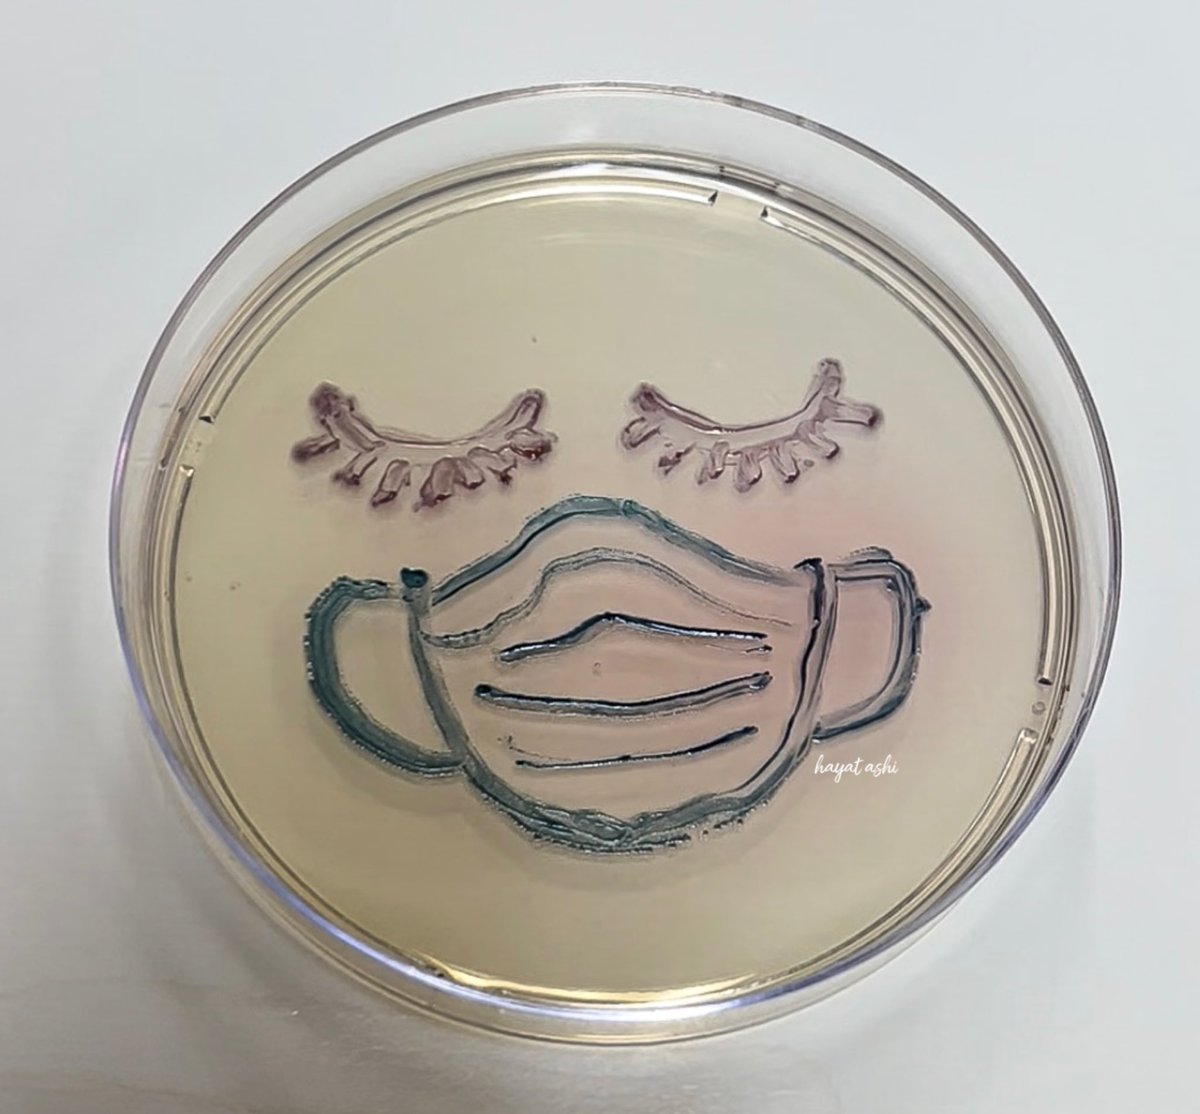

العدوى من حامل المرض بتكون ضعيفه جدا جدا ولو حصلت بتكون بلا أعراض أو بأعراض بسيطه لأن الفيروس بيكون خامل جدا وجهاز المناعة سيطر عليه بشكل كبير.
ثانيا
✅ذوى الأعراض البسيطة كأحتقان الحلق وحرقان وجفاف الريق بالفم والحلق وحكه الأنف مع فقدان لحاسة الشم والتذوق وارتفاع متباعد وعلى
ثانيا
✅ذوى الأعراض البسيطة كأحتقان الحلق وحرقان وجفاف الريق بالفم والحلق وحكه الأنف مع فقدان لحاسة الشم والتذوق وارتفاع متباعد وعلى
فترات بدرجات الحراره وهؤلاء يمثلوا10% من إجمالى الحالات ولاخوف عليهم ولكنهم سبب في نقل الهدى ولكن أيضا العدوة بتكون ضعيفة بدون أعراض أو أعراض بسيطه لأن الفيروس بيكون عاجز أمام جهاز المناعه القوي
ثالثا
✅ذو الأعراض التنفسيه (Active patients)
وهذه أخطر فئه بتمثل تقريبا 5% فقط
ثالثا
✅ذو الأعراض التنفسيه (Active patients)
وهذه أخطر فئه بتمثل تقريبا 5% فقط
من إجمالى المصابين وأعراضهم سعال جاف متقطع بيزيد مع النوم او بذل المجهود او الكلام،ضيق بالتنفس ، ثقل بالصدر أو نغزات وعدم شعور بالراحه أو حرقة الصدر ، هذه الفئة تكون معدية جدا درجة بشكل كبير لدرجة أن اي شخص يتعاملمعاهم بيتعدوا وغالبا هذه الفئة يتم عزلها في المستشفى نظرآ لنشاط
الفيروس وتخطيه قدره المناعه.
🙋🏼♀️ملحوظة
-فتره الحضانه من ٣ أيام إلى ١٤ يوم ولكن فى حاله مخالطة مريض من الدرجة الثالثة فتظهر الأعراض فى خلال ٣ أيام على أقصى تقدير.
⁃لا تقم بعمل مسحة إلا لو أنت مخالط لحاله إيجابيه مؤكده وكانت نشطه وواضح عليها أعراض تنفسيه وانت كذلك( سعال جاف متقطع
🙋🏼♀️ملحوظة
-فتره الحضانه من ٣ أيام إلى ١٤ يوم ولكن فى حاله مخالطة مريض من الدرجة الثالثة فتظهر الأعراض فى خلال ٣ أيام على أقصى تقدير.
⁃لا تقم بعمل مسحة إلا لو أنت مخالط لحاله إيجابيه مؤكده وكانت نشطه وواضح عليها أعراض تنفسيه وانت كذلك( سعال جاف متقطع
ضيق بالتنفس، آلم بالصدر،حرقه بالصدر، ثقل بالصدر) غير ذلك يكتفى بعزل نفسك لمده ١٤ يوم مع اتباع الارشادات اللازمة للتعافي
⁃الحالات الإيجابيه المؤكده بمسحه وكانت بدون أعراض أو أعراض بسيطه تعزل نفسها منزليآ فقط مع تواصل مع طبيب يوميآ بشرط عدم وجود أعراض تنفسيه متقدمه.
⁃الحالات الإيجابيه المؤكده بمسحه وكانت بدون أعراض أو أعراض بسيطه تعزل نفسها منزليآ فقط مع تواصل مع طبيب يوميآ بشرط عدم وجود أعراض تنفسيه متقدمه.
⁃الأطفال فى مأمن ولا خوف عليهم باذن الله حتى في حال ثبت اصابتهم
⁃الفئات الحساسه المهدده بالخطر ( كبار السن ، مرضى الأمراض المزمنه والحالات الحرجه والأمراض المناعيه)
دون ذلك أنت فى أمان باذن الله إلا في حال وجود مرض مزمن أو حرج غير مشخص
⁃الفئات الحساسه المهدده بالخطر ( كبار السن ، مرضى الأمراض المزمنه والحالات الحرجه والأمراض المناعيه)
دون ذلك أنت فى أمان باذن الله إلا في حال وجود مرض مزمن أو حرج غير مشخص
✅ العدوى بنسبه 99 % بتحصل نتيجه التعامل مع مريض ظاهر عليه الأعراض بشكل نشط ، ونادر جدا جدا أنها تتنقل عن طريق الأسطح أو المفروشات أو متعلقات المريض لأن الحد الأدنى من جرعه الفيروس المعدية على الأسطح ليست متوفره عاده وبتكون أقل من أنها تسبب
جاري تحميل الاقتراحات...